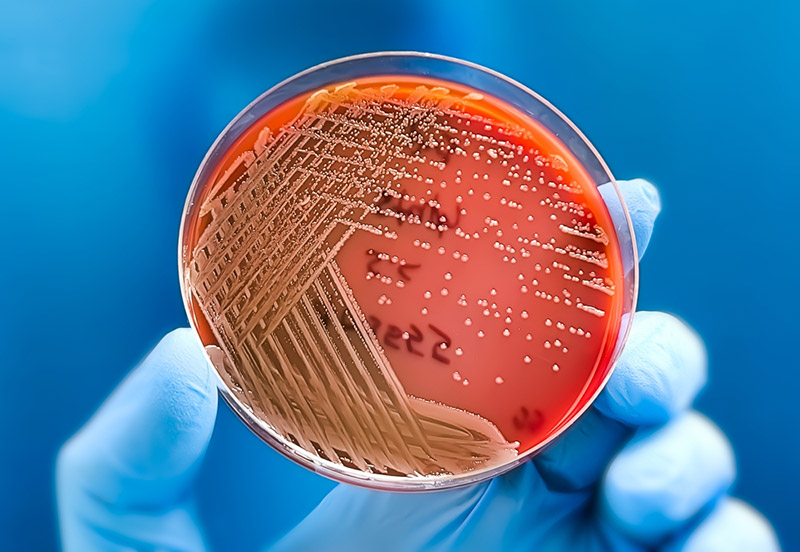
Môi Trường Nuôi Cấy Vi Sinh Là Gì? Định Nghĩa, Phân Loại Môi Trường Nuôi Cấy Vi Sinh
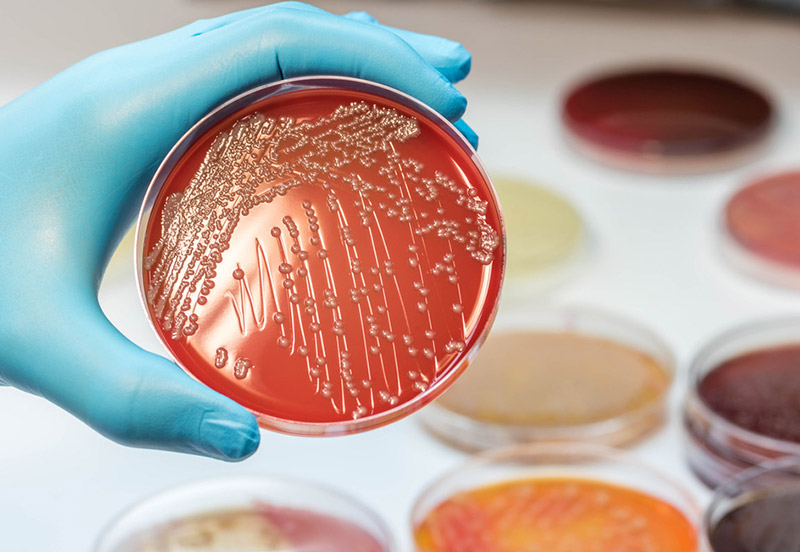
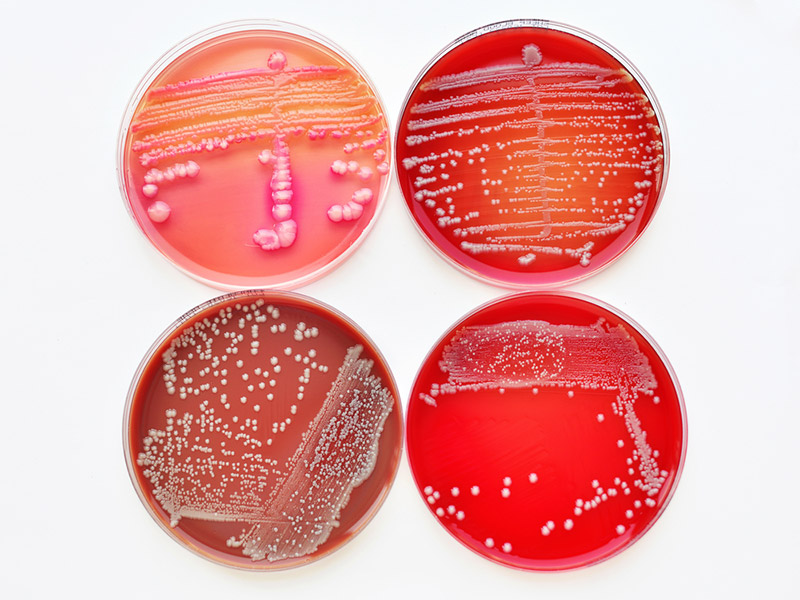

Môi Trường Nuôi Cấy Vi Sinh Là Gì? Định Nghĩa, Phân Loại Môi Trường Nuôi Cấy Vi Sinh
Trong lĩnh vực vi sinh học, việc nghiên cứu và ứng dụng vi sinh vật đóng vai trò vô cùng quan trọng. Để có thể nuôi cấy, phân lập, quan sát, phân tích và khai thác tiềm năng của các vi sinh vật, chúng ta cần tạo ra một “ngôi nhà” lý tưởng cho chúng phát triển – đó chính là môi trường nuôi cấy vi sinh. Bài viết này sẽ giúp bạn hiểu rõ về môi trường nuôi cấy vi sinh vật, các loại môi trường phổ biến và ứng dụng của chúng trong quy trình nuôi cấy cũng như trong phòng thí nghiệm.
Môi Trường Nuôi Cấy Vi Sinh Vật Là Gì?
Định Nghĩa
Môi trường nuôi cấy vi sinh vật (hay còn gọi là môi trường vi sinh) là một hỗn hợp các chất dinh dưỡng (dưới dạng lỏng, bán rắn hoặc rắn), khoáng chất và các yếu tố cần thiết khác được thiết kế đặc biệt để cung cấp điều kiện tối ưu cho sự sinh trưởng và phát triển của vi sinh vật (vi khuẩn, nấm) trong điều kiện phòng thí nghiệm hoặc sản xuất công nghiệp.
Môi trường nuôi cấy đóng vai trò như một hệ sinh thái nhân tạo, mô phỏng môi trường sống tự nhiên của vi sinh vật. Nó cung cấp đầy đủ các nguồn dinh dưỡng cần thiết bao gồm nguồn cacbon, nitơ, năng lượng, vitamin, khoáng chất và các yếu tố tăng trưởng khác.
Các loại phổ biến gồm môi trường cơ bản (Luria Broth – LB), môi trường tăng sinh (BHI), môi trường chọn lọc (MacConkey, EMB) và môi trường biệt hóa (TCBS), được phân loại theo thành phần (tự nhiên, tổng hợp, bán tổng hợp) và mục đích sử dụng.
Việc lựa chọn môi trường nuôi cấy đúng là yếu tố quyết định thành công của quá trình nuôi cấy vi sinh vật trong phòng thí nghiệm
Tầm Quan Trọng Của Môi Trường Nuôi Cấy
Việc sử dụng môi trường nuôi cấy vi sinh vật là nền tảng cho nhiều hoạt động quan trọng:
- Trong quy trình nuôi cấy vi sinh: Việc phân loại và lựa chọn đúng môi trường nuôi cấy là bước đầu tiên, quan trọng quyết định sự thành công của quy trình nuôi cấy vi sinh trong phòng thí nghiệm
- Trong nghiên cứu khoa học: Phân lập, nuôi cấy và nhận diện các chủng vi sinh vật mới. Nghiên cứu đặc điểm sinh lý, sinh hóa của vi sinh vật. Nghiên cứu di truyền và tiến hóa vi sinh vật. Phát triển các công nghệ sinh học mới
- Trong y học và lâm sàng: Chẩn đoán bệnh truyền nhiễm. Xác định tác nhân gây bệnh. Thử nghiệm độ nhạy cảm với kháng sinh. Phát triển vaccine và thuốc kháng sinh
- Trong công nghiệp: Sản xuất thực phẩm lên men (sữa chua, phô mai, rượu, bia). Sản xuất enzyme và các hợp chất sinh học. Kiểm tra chất lượng thực phẩm và nước uống. Sản xuất các chế phẩm vi sinh nông nghiệp
Yêu Cầu Cơ Bản Của Môi Trường Nuôi Cấy
Một môi trường nuôi cấy hoàn chỉnh cần đáp ứng các yêu cầu sau:
Về thành phần dinh dưỡng:
- Nguồn cacbon: glucose, sucrose, mannitol hoặc các hợp chất hữu cơ khác
- Nguồn nitơ: peptone, cao men, muối amoni, nitrat
- Nguồn năng lượng: các hợp chất hữu cơ có thể bị oxy hóa
- Nguyên tố vi lượng: sắt, magie, kẽm, đồng và các kim loại khác
- Vitamin và yếu tố tăng trưởng
Về tính chất vật lý:
- Độ pH phù hợp (thường từ 6.5-7.5)
- Nhiệt độ tối ưu (tùy loại vi sinh vật)
- Áp suất thẩm thấu cân bằng
- Nồng độ oxy phù hợp
Về độ tinh khiết:
- Vô trùng, không có vi sinh vật lạ
- Không chứa chất ức chế hoặc độc tố
- Đồng nhất về thành phần
Phân Loại Môi Trường Nuôi Cấy Vi Sinh Vật như thế nào?

Môi trường nuôi cấy vi sinh vật có thể được phân loại theo 3 tiêu chí chính. Cụ thể là:
- Phân loại theo độc đặc
- Phân loại theo thành phần dinh dưỡng
- Phân loại theo mục đích sử dụng
Phân Loại Theo Độ Đặc (Tính Nhất Quán Vật Lý)
Môi Trường Rắn (Solid)
Đặc điểm: Chứa chất đông đặc như agar (nồng độ 1.5-2.0%) hoặc gelatin. Có độ cứng nhất định, tạo bề mặt phẳng để vi sinh vật phát triển. Đông đặc ở nhiệt độ phòng sau khi được làm nóng chảy
Ứng dụng: Phân lập vi sinh vật thuần khiết từ mẫu hỗn hợp. Quan sát hình thái khuẩn lạc. Đếm số lượng vi sinh vật. Bảo quản giống vi sinh vật
Ví dụ điển hình:
- Nutrient Agar: môi trường cơ bản cho vi khuẩn không khó tính
- Blood Agar: môi trường tăng sinh chứa 5-10% máu
- MacConkey Agar: môi trường chọn lọc cho vi khuẩn gram âm
- Sabouraud Dextrose Agar: môi trường cho nấm men và nấm mốc
Ưu điểm: Dễ quan sát đặc điểm khuẩn lạc. Thuận tiện cho việc phân lập và bảo quản. Có thể thực hiện nhiều thử nghiệm sinh hóa trực tiếp trên bề mặt
Nhược điểm: Khó áp dụng cho sản xuất quy mô lớn. Không phù hợp với vi sinh vật yêu cầu môi trường lỏng
Môi Trường Bán Rắn (Semi-Solid)
Đặc điểm: Chứa agar ở nồng độ thấp (0.2-0.5%). Có độ mềm, giống như thạch. Không đông cứng hoàn toàn, có tính đàn hồi
Ứng dụng chính: Nghiên cứu khả năng di động của vi khuẩn. Phân biệt giữa vi khuẩn có khả năng di động và không di động. Bảo quản giống vi sinh vật trong thời gian dài. Nuôi cấy vi khuẩn vi hiếu khí
Ví dụ:
- Môi trường Hugh-Leifson OF (Oxidation-Fermentation)
- Môi trường SIM (Sulfide-Indole-Motility)
- Môi trường vận chuyển Stuart và Amies
- Môi trường Mannitol Motility
Kỹ thuật sử dụng: Cấy đâm sâu bằng kim cấy thẳng từ bề mặt xuống đáy ống. Vi khuẩn di động sẽ lan tỏa ra khỏi đường cấy. Vi khuẩn không di động chỉ phát triển dọc theo đường cấy
Môi Trường Lỏng (Liquid)
Đặc điểm: Không chứa chất đông đặc. Có dạng dung dịch trong suốt hoặc hơi đục. Vi sinh vật phân bố đều trong toàn bộ thể tích mẫu
Ứng dụng: Nuôi cấy sinh khối vi sinh vật lớn. Sản xuất các sản phẩm chuyển hóa (enzyme, kháng sinh, acid hữu cơ). Nghiên cứu sinh lý, sinh hóa vi sinh vật. Tăng sinh vi sinh vật trước khi phân lập. Thực hiện các thử nghiệm lên men
Ví dụ:
- Nutrient Broth: môi trường cơ bản dạng lỏng
- Tryptic Soy Broth (TSB): môi trường giàu dinh dưỡng
- Phenol Red Carbohydrate Broth: thử nghiệm lên men đường
- MR-VP Broth: thử nghiệm Methyl Red và Voges-Proskauer
- Selenite Broth: tăng sinh Salmonella từ phân
Ưu điểm: Phù hợp cho sản xuất quy mô công nghiệp. Vi sinh vật phát triển nhanh và đồng đều. Dễ dàng lấy mẫu và đo đạc các thông số. Có thể sục khí hoặc khuấy trộn
Nhược điểm: Khó phân lập khuẩn lạc đơn. Dễ bị nhiễm khuẩn lan rộng. Không quan sát được hình thái khuẩn lạc
Phân Loại Theo Thành Phần Dinh Dưỡng
Môi Trường Đơn Giản (Simple/Basal)
Đặc điểm: Chứa các thành phần dinh dưỡng cơ bản nhất. Không cần bổ sung yếu tố tăng trưởng đặc biệt. Thành phần gồm: nguồn C, N, nước, muối khoáng
Thích hợp cho: Vi khuẩn không khó tính (non-fastidious bacteria). Vi sinh vật có khả năng tổng hợp tất cả các hợp chất cần thiết. Nuôi cấy và bảo quản thông thường
Ví dụ:
- Nutrient Broth/Agar
- Peptone Water
- Tryptose Soy Broth/Agar
Môi Trường Phức Tạp (Complex)
Đặc điểm: Chứa nhiều thành phần dinh dưỡng với nồng độ không xác định chính xác. Được chuẩn bị từ các nguồn tự nhiên (cao thịt, cao men, peptone). Giàu dinh dưỡng, phù hợp với nhiều loại vi sinh vật
Thành phần thường gặp: Peptone – cung cấp nitrogen, amino acid. Cao thịt – cung cấp vitamin B, khoáng chất. Cao men – cung cấp vitamin nhóm B, acid amin. Các muối khoáng
Ví dụ:
- Brain Heart Infusion (BHI) Broth/Agar
- Tryptic Soy Broth (TSB)
- Chocolate Agar
- Blood Agar Base
Môi Trường Tổng Hợp (Synthetic/Defined)
Đặc điểm: Có thành phần hóa học xác định rõ ràng. Được pha chế từ các hóa chất tinh khiết. Nồng độ từng thành phần được biết chính xác
Ứng dụng: Nghiên cứu nhu cầu dinh dưỡng của vi sinh vật. Nghiên cứu chuyển hóa và sinh tổng hợp. Thí nghiệm định lượng chính xác. Sản xuất dược phẩm yêu cầu độ tinh khiết cao
Ví dụ:
- Môi trường M9 Minimal Medium
- Môi trường Davis Minimal Medium
- Môi trường xác định cho E. coli, Bacillus subtilis
Ưu điểm: Kiểm soát chính xác thành phần. Tái lập cao trong nghiên cứu. Phù hợp cho nghiên cứu cơ chế sinh hóa
Nhược điểm: Chi phí cao. Chỉ một số vi sinh vật có thể phát triển. Chuẩn bị phức tạp, tốn thời gian
Phân Loại Theo Mục Đích Sử Dụng
Môi Trường Cơ Bản (General Purpose)
Đặc điểm: Là môi trường đa năng, không có tính chọn lọc. Hỗ trợ hầu hết các vi khuẩn không khó tính. Thành phần đơn giản, chi phí thấp
Ứng dụng: Phân lập sơ bộ vi sinh vật. Nuôi cấy và bảo quản thường quy. Làm nền để bổ sung tạo môi trường chuyên dụng
Ví dụ điển hình:
- Nutrient Agar/Broth: môi trường phổ biến nhất trong phòng lab
- Peptone Water: môi trường lỏng đơn giản
- Tryptic Soy Agar/Broth: môi trường giàu dinh dưỡng hơn
Thành phần cơ bản: Peptone (5-10 g/L). Cao thịt hoặc cao men (3-5 g/L). NaCl (5 g/L). Agar nếu là môi trường rắn (15-20 g/L)
Môi Trường Tăng Sinh (Enriched)
Đặc điểm: Được bổ sung thêm các yếu tố tăng trưởng đặc biệt. Cung cấp dinh dưỡng phong phú cho vi sinh vật khó tính. Thường bổ sung máu, huyết thanh, lòng đỏ trứng
Vi sinh vật mục tiêu: Vi khuẩn khó tính (fastidious bacteria). Vi khuẩn yêu cầu yếu tố tăng trưởng đặc biệt. Vi khuẩn bệnh lý quan trọng
Các loại môi trường tăng sinh:
- Blood Agar (Thạch Máu): Bổ sung 5-10% máu cừu hoặc máu ngựa. Quan sát khả năng tan máu: α, β, γ hemolysis. Phân lập Streptococcus, Staphylococcus
- Chocolate Agar (Thạch Sô-cô-la): Máu được đun nóng đến 80°C làm vỡ tế bào hồng cầu. Giải phóng hemin (yếu tố X) và NAD (yếu tố V). Phân lập Neisseria gonorrhoeae, Haemophilus influenzae
- Loeffler’s Serum Slope: Chứa huyết thanh bò. Nuôi cấy Corynebacterium diphtheriae
- Egg Yolk Agar: Bổ sung lòng đỏ trứng. Phát hiện hoạt tính lecithinase của Clostridium perfringens
Môi Trường Chọn Lọc (Selective)
Nguyên lý: Chứa các chất ức chế chọn lọc. Ức chế sự phát triển của một số vi sinh vật. Cho phép vi sinh vật mục tiêu phát triển
Các tác nhân chọn lọc:
- Muối mật: ức chế vi khuẩn gram dương
- Nồng độ muối cao (7-10% NaCl): chỉ Staphylococcus chịu được
- Kháng sinh: ức chế vi khuẩn nhạy cảm
- Thuốc nhuộm: crystal violet, brilliant green ức chế gram dương
- pH cực đoan: pH 8.5-9.0 cho Vibrio cholerae
Ví dụ quan trọng:
- MacConkey Agar: Chứa muối mật và crystal violet. Chọn lọc vi khuẩn gram âm (Enterobacteriaceae). Phân biệt vi khuẩn lên men lactose (hồng) và không lên men (trắng)
- Mannitol Salt Agar (MSA): Chứa 7.5% NaCl. Chọn lọc Staphylococcus species. Phân biệt S. aureus (lên men mannitol – màu vàng) và Staphylococcus khác
- Eosin Methylene Blue (EMB) Agar: Chứa eosin Y và methylene blue. Chọn lọc vi khuẩn gram âm. E. coli tạo khuẩn lạc kim loại xanh-đen
- Thayer-Martin Agar: Chứa nhiều kháng sinh (vancomycin, colistin, nystatin). Chọn lọc Neisseria gonorrhoeae và N. meningitidis
- Lowenstein-Jensen Medium: Chứa malachite green. Chọn lọc Mycobacterium tuberculosis
- TCBS Agar (Thiosulfate Citrate Bile Salts Sucrose): pH cao 8.5-8.6. Chọn lọc Vibrio species từ mẫu phân
Môi Trường Tăng Sinh Chọn Lọc (Selective Enrichment)
Đặc điểm: Kết hợp tính chất tăng sinh và chọn lọc. Dạng lỏng, tăng mật độ vi sinh vật mục tiêu. Sử dụng trước khi cấy lên môi trường rắn chọn lọc
Ứng dụng: Phục hồi vi sinh vật từ mẫu có số lượng thấp. Tăng tỷ lệ vi sinh vật mục tiêu so với vi sinh vật cộng sinh. Phân lập mầm bệnh từ mẫu lâm sàng
Ví dụ:
- Selenite F Broth: Chứa sodium selenite (ức chế gram dương và E. coli). Tăng sinh Salmonella từ mẫu phân. Được Ủ trong vòng 12-18 giờ ở 37°C
- Tetrathionate Broth: Chứa thiosulfate và iodine. Tăng sinh Salmonella. Ít ức chế hơn Selenite F
- Alkaline Peptone Water (APW): pH 8.5-9.0. Tăng sinh Vibrio cholerae. Ủ 6-8 giờ
- Gram-Negative (GN) Broth: Tăng sinh Salmonella và Shigella. Ức chế gram dương và Proteus
Môi Trường Phân Biệt /Chỉ Thị ( Differential/ Indicator)
Nguyên lý: Chứa chất chỉ thị màu hoặc hóa chất phản ứng. Tạo ra màu sắc hoặc hiện tượng khác nhau. Phân biệt vi sinh vật dựa trên hoạt tính sinh hóa
Cơ chế hoạt động:
- Lên men đường → thay đổi pH → đổi màu chỉ thị
- Tan máu → tạo vùng trong suốt hoặc xanh lục
- Sản xuất H2S → kết tủa đen
- Thủy phân protein → vùng trong suốt quanh khuẩn lạc
Ví dụ chi tiết:
- Blood Agar – Phân Biệt Khả Năng Tan Máu
- MacConkey Agar – Phân Biệt Lên Men Lactose
- Mannitol Salt Agar
- TCBS Agar
- Xylose Lysine Deoxycholate (XLD) Agar
- Triple Sugar Iron (TSI) Agar
Môi Trường vi sinh chuyển (Transport)
Mục đích: Bảo quản mẫu trong quá trình vận chuyển. Duy trì khả năng sống của vi sinh vật. Ngăn ngừa khô, nhiễm khuẩn và tăng sinh quá mức
Đặc điểm: Dạng bán rắn (0.3-0.5% agar). Không chứa nguồn dinh dưỡng dồi dào. Có chất đệm duy trì pH. Thường bổ sung than hoạt tính (trung hòa chất độc)
Ví dụ:
- Stuart’s Transport Medium: Môi trường tối giản với sodium glycerophosphate. Bổ sung than hoạt tính. Vận chuyển mẫu cổ họng, niệu đạo
- Amies Transport Medium: Cải tiến từ Stuart’s medium. Bổ sung charcoal. Phù hợp cho vi khuẩn kỵ khí tùy ý
- Cary-Blair Transport Medium: pH cao (8.4), ít dinh dưỡng. Vận chuyển mẫu phân nghi Vibrio cholerae. Bảo quản tốt trong 4 tuần ở nhiệt độ phòng
- Buffered Glycerol Saline: Vận chuyển mẫu phân nghi Shigella. Chứa glycerol giúp bảo quản
- Pike’s Medium: Vận chuyển Streptococcus từ mẫu cổ họng. Chứa thạch và glucose
Môi Trường Kỵ Khí (Anaerobic)
Đặc điểm: Thiết kế cho vi khuẩn kỵ khí bắt buộc. Loại bỏ hoặc giảm thiểu oxy hòa tan. Bổ sung chất khử (thioglycollate, cysteine). Thêm hemin và vitamin K
Phương pháp khử oxy: Đun sôi và làm nguội nhanh. Bổ sung chất khử hóa học. Tạo lớp dầu hoặc paraffin che phủ. Sử dụng chỉ thị oxy hóa-khử
Ví dụ:
- Thioglycollate Broth: Chứa sodium thioglycollate (chất khử mạnh). Glucose, L-cystine. Resazurin hoặc methylene blue (chỉ thị). Màu hồng khi có oxy, không màu khi khử. Ứng dụng trong nuôi cấy và kiểm tra độ vô trùng
- Robertson’s Cooked Meat Medium (RCM): Chứa thịt bò đực nấu chín. Nước dùng dinh dưỡng. Nuôi cấy Clostridium species. Phát hiện C. perfringens gây ngộ độc thực phẩm
- Egg Yolk Agar (Neomycin): Bổ sung neomycin ức chế vi khuẩn gram âm. Phát hiện lecithinase của Clostridium
- Blood Agar (Anaerobic): Bổ sung hemin, vitamin K, L-cysteine. Nuôi cấy Bacteroides fragilis
Môi Trường Phân Tích (Assay)
Mục đích: Định lượng vitamin, amino acid. Xét nghiệm hoạt lực kháng sinh. Phân tích hoạt tính enzyme. Nghiên cứu nhu cầu dinh dưỡng
Ứng dụng:
- Antibiotic Assay Medium: Xác định hoạt lực kháng sinh. Kiểm tra độ nhạy cảm vi khuẩn. Thử nghiệm vi sinh định lượng kháng sinh
- Vitamin Assay Medium: Định lượng vitamin B12, thiamine, niacin. Sử dụng vi sinh vật chuẩn
- Amino Acid Assay Medium: Định lượng lysine, methionine và các amino acid khác
Môi Trường Lưu Trữ (Storage)
Mục đích: Bảo quản giống vi sinh vật dài hạn. Duy trì hoạt lực và đặc tính di truyền. Ngăn ngừa đột biến và thoái hóa
Ví dụ:
- Cooked Meat Medium với phấn
- Egg Saline Medium
- Glycerol stock (20-50% glycerol ở -80°C)
- Lyophilized cultures (lạnh đông khô)
Các Yếu Tố Ảnh Hưởng Đến Môi Trường Nuôi Cấy là gì?
Có 3 yếu tố chính ảnh hưởng đến môi trường nuôi cấy vi sinh vật, bao gồm: yếu tố thành phần dinh dưỡng, các yếu tố vật lý, yếu tố về mặt thời gian:
Yếu Tố Dinh Dưỡng
- Nguồn cacbon: Glucose, lactose, sucrose. Các acid hữu cơ. Protein thủy phân
- Nguồn nitơ: Peptone (protein thủy phân). Cao men, cao thịt. Muối amoni, nitrat
- Nguyên tố vi lượng: Fe, Mg, Mn, Zn, Cu, Co. Cần thiết cho enzyme và protein
- Vitamin và yếu tố tăng trưởng: Vitamin B complex. Hemin, NAD. Các hormone tăng trưởng
Yếu Tố Vật Lý
Độ pH môi trường nuôi cấy:
- Vi khuẩn: pH 6.5-7.5 (trung tính)
- Nấm men: pH 5.0-6.0 (axit nhẹ)
- Nấm mốc: pH 4.0-5.5 (axit)
- Vi khuẩn ưa kiềm: pH 8.5-9.0
Nhiệt độ môi trường nuôi cấy:
- Ưa lạnh (Psychrophiles): 0-20°C
- Ưa ấm (Mesophiles): 20-45°C (phổ biến nhất)
- Ưa nóng (Thermophiles): 45-70°C
- Ưa nóng cực đoan: >70°C
Hàm lượng khí Oxy:
- Hiếu khí bắt buộc: cần O₂
- Kỵ khí bắt buộc: không chịu được O₂
- Kỵ khí tùy ý: phát triển tốt nhất có O₂ nhưng có thể sống không O₂
- Vi hiếu khí: cần O₂ nồng độ thấp (2-10%)
Áp suất thẩm thấu:
- Ưa muối (Halophiles): 3-15% NaCl
- Ưa đường (Osmophiles): nồng độ đường cao
- Hầu hết vi khuẩn: 0.85% NaCl
Yếu Tố Thời Gian
Thời gian ủ:
- Vi khuẩn thường: 18-24 giờ
- Vi khuẩn chậm: 3-7 ngày
- Mycobacterium: 3-8 tuần
- Nấm: 3-7 ngày
Pha sinh trưởng:
- Pha lag (thích nghi): 0-4 giờ
- Pha log (tăng trưởng mũi): 4-12 giờ
- Pha đứng (cân bằng): 12-24 giờ
- Pha suy vong: sau 24 giờ
Ứng Dụng Thực Tiễn Của Môi Trường Nuôi Cấy

Trong Y Học
- Chẩn đoán bệnh truyền nhiễm: Cấy máu, nước tiểu, dịch não tủy Phân lập và định danh mầm bệnh. Xét nghiệm kháng sinh đồ
- Phát triển vaccine: Nuôi cấy vi sinh vật sản xuất kháng nguyên. Nghiên cứu đáp ứng miễn dịch
Trong Công Nghiệp Thực Phẩm
- Sản xuất thực phẩm lên men: Sữa chua (Lactobacillus, Streptococcus), Phô mai (Lactococcus, Propionibacterium), Rượu, bia (Saccharomyces), Nước tương, tương ớt (Aspergillus)
- Kiểm tra chất lượng: Đếm vi sinh vật tổng số, Phát hiện vi sinh vật chỉ thị, Kiểm tra mầm bệnh (Salmonella, E. coli O157:H7, Listeria)
Trong Nông Nghiệp
- Chế phẩm vi sinh: Phân bón sinh học (Rhizobium, Azotobacter), Thuốc trừ sâu sinh học (Bacillus thuringiensis), Kích thích sinh trưởng thực vật
- Kiểm tra bệnh cây trồng: Phân lập vi khuẩn gây bệnh, Nghiên cứu mầm bệnh mới
Trong Công Nghiệp Sinh Học
- Sản xuất enzyme: Amylase, protease, lipase, Cellulase cho sản xuất bioethanol
- Sản xuất kháng sinh: Penicillin từ Penicillium, Streptomycin từ Streptomyces
- Sản xuất acid hữu cơ: Acid citric (Aspergillus niger), Acid glutamic (Corynebacterium glutamicum)
Trong Xử Lý Môi Trường
- Xử lý nước thải: Vi sinh vật phân hủy chất hữu cơ. Loại bỏ nitrogen, phosphorus
- Phân hủy chất độc: Vi sinh vật phân hủy dầu mỏ, Phân hủy thuốc trừ sâu
Quy Trình Chuẩn Bị Môi Trường Nuôi Cấy
Dưới đây là quy trình 7 bước tiêu chuẩn chuẩn bị môi trường nuôi cấy phổ biến trong nhiều phòng thí nghiệm vi sinh:
Bước 1: Cân Các Thành Phần
Sử dụng cân phân tích chính xác (3 số lẻ). Cân đúng tỷ lệ theo công thức. Ghi chép cẩn thận

Bước 2: Hòa Tan
Thêm nước cất từ từ. Khuấy đều cho đến khi tan hoàn toàn. Đun nhẹ nếu cần thiết
Bước 3: Điều Chỉnh độ pH
Sử dụng máy đo pH. Thêm HCl hoặc NaOH để điều chỉnh. Kiểm tra lại sau khi khử trùng

Bước 4: Phân Phối
Rót vào bình, ống nghiệm. Đậy nắp hoặc bịt bông. Ghi nhãn rõ ràng cho từng loại môi trường
Bước 5: Khử Trùng
Phương pháp khử trùng môi trường nuôi cấy phổ biến:
- Hấp tiệt trùng (Autoclave): ở nhiệt độ hấp tiệt trùng tiêu chuẩn 121°C, 15 psi, 15-20 phút

- Lọc vô trùng: dùng màng lọc 0.22 μm (cho chất nhạy nhiệt)
- Thanh trùng gián đoạn (Tyndallization): 80°C x 30 phút x 3 ngày
Lưu ý: Không khử trùng quá nhiệt độ, thời gian. Kiểm tra chỉ thị sinh học. Để nguội từ từ sau khử trùng
Bước 6: Kiểm Tra Chất Lượng
- Kiểm tra vô trùng: Ủ một phần môi trường ở 37°C/24h. Không được có sự phát triển vi sinh vật
- Kiểm tra hiệu quả: Cấy giống chuẩn. Đánh giá khả năng sinh trưởng. So sánh với lô trước
- Kiểm tra đặc tính: Màu sắc; Độ pH; Độ trong / đục; Độ đặc
Bước 7: Bảo Quản
- Môi trường rắn: 2-8°C, tối, 1-3 tháng
- Môi trường lỏng: 2-8°C, tối, 2-4 tuần
- Tránh ánh sáng trực tiếp
- Kiểm tra định kỳ
Các Lỗi Thường Gặp Và Cách Khắc Phục
Một vài lưu ý, lỗi thường gặp trong quá trình chuẩn bị môi trường nuôi cấy vi sinh vật và cách khắc phục được Thiết bị Hiệp Phát tổng hợp:
Môi Trường Bị Nhiễm Khuẩn
Nguyên nhân:
- Khử trùng không đủ nhiệt độ/thời gian
- Nhiễm khuẩn sau khử trùng
- Bảo quản không đúng
Khắc phục:
- Kiểm tra lại quy trình khử trùng
- Sử dụng chỉ thị sinh học
- Thực hành vô trùng nghiêm ngặt
Môi Trường Không Đông
Nguyên nhân:
- Nồng độ agar không đủ
- pH quá thấp làm thủy phân agar
- Khử trùng quá lâu
Khắc phục:
- Tăng nồng độ agar lên 1.8-2.0%
- Điều chỉnh pH về 7.0-7.2
- Giảm thời gian khử trùng xuống 15 phút
Môi Trường Đổi Màu
Nguyên nhân:
- Oxy hóa các thành phần
- Ánh sáng làm phân hủy
- Bảo quản quá lâu
Khắc phục:
- Bảo quản nơi tối
- Sử dụng trong thời hạn
- Chuẩn bị lượng vừa đủ
Vi Sinh Vật Không Phát Triển
Nguyên nhân:
- Môi trường không phù hợp
- Nhiệt độ ủ không đúng
- Vi sinh vật chết do nhiệt/hóa chất
Khắc phục:
- Kiểm tra lại công thức môi trường
- Điều chỉnh nhiệt độ, khí quyển
- Sử dụng môi trường tươi
Kết Luận
Môi trường nuôi cấy vi sinh vật là công cụ không thể thiếu trong nghiên cứu và ứng dụng vi sinh học. Việc hiểu rõ về định nghĩa, phân loại và cách sử dụng các loại môi trường sẽ giúp các nhà khoa học, kỹ thuật viên phòng thí nghiệm lựa chọn và sử dụng môi trường một cách hiệu quả nhất. Bên cạnh đó, Công ty TNHH Thiết bị Hiệp Phát hiện đang là nhà phân phối các dòng thiết bị phòng thí nghiệm vi sinh, đáp ứng đầy đủ tiêu chí cho quy trình nuôi cấy môi trường vi sinh vật đạt chuẩn. Nếu quý khách hàng đang có nhu cầu tìm mua các dòng thiết bị phòng vi sinh, đừng ngần ngại liên hệ với Hiệp Phát qua Sđt: 0919.537.653 – Mr. Tú hoặc Email: sales5@thietbihiepphat.com để được hỗ trợ kịp thời.

Để lại thắc mắc, chúng tôi sẽ giải đáp ngay cho bạn



 VN
VN














